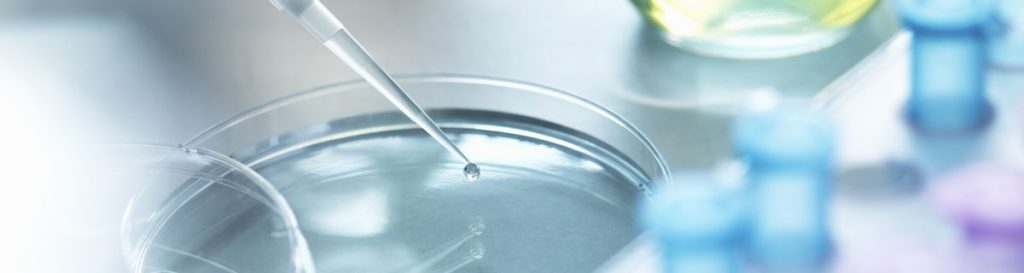

Da una piccola realtà italiana a punto di riferimento europeo: in oltre 50 anni di storia, Eurosirel ha saputo evolversi costantemente, anticipando i trend del mercato care & beauty e costruendo relazioni solide con le principali catene farmaceutiche, retailer e multinazionali del settore.
Oggi produciamo oltre 1,5 miliardi di unità all’anno, operando in tutto il mondo in più di 60 Paesi con una filiera integrata e certificata.
La nostra crescita si fonda su un modello end-to-end che unisce innovazione proprietaria, qualità rigorosa e capacità di adattamento.
Essere un CDMO di riferimento non è un traguardo, ma una responsabilità che ci guida nell’evolvere ogni giorno al fianco dei nostri clienti, per progettare insieme il futuro del self-care e della bellezza.
I NOSTRI NUMERI
2025
FONDAMENTALI
Innovazione
L’innovazione è parte integrante del nostro DNA. Ogni anno reinvestiamo una quota rilevante del fatturato in R&D per progettare soluzioni uniche, brevettate e ad alto valore tecnologico. Dal laboratorio alla produzione, innoviamo per migliorare la qualità della vita delle persone.

Sostenibilità
Crediamo in una crescita responsabile e duratura. Selezioniamo materie prime naturali e performanti, ottimizziamo i processi produttivi e sviluppiamo packaging sostenibili, riducendo l’impatto ambientale lungo tutta la filiera. La nostra innovazione è sempre al servizio del pianeta.

Persone
Le persone sono la nostra risorsa più preziosa. Valorizziamo il talento, promuoviamo la formazione continua e coltiviamo un ambiente di lavoro inclusivo e collaborativo. Solo con team affiatati e orientati al cliente possiamo creare valore e costruire il futuro.
MISSION
Permettiamo a tutti i cittadini del mondo di godere di trattamenti di auto-cura di salute e bellezza, accessibili e di qualità.
Ogni giorno.
STORIES

Lorem ipsum docet
Lorem ipsum dolor sit amet, consectetur adipiscing elit, sed do eiusmod tempor incididunt ut labore et dolore magna aliqua. Lorem ipsum dolor sit amet, consectetur adipiscing elit, sed do eiusmod tempor incididunt ut labore et dolore magna aliqua.
Lorem ipsum docet
Lorem ipsum dolor sit amet, consectetur adipiscing elit, sed do eiusmod tempor incididunt ut labore et dolore magna aliqua. Lorem ipsum dolor sit amet, consectetur adipiscing elit, sed do eiusmod tempor incididunt ut labore et dolore magna aliqua.

INSIEME DA 50 ANNI

Leonelli fonda Sirel®

Prima catena estero, cambio ragione sociale/logo








